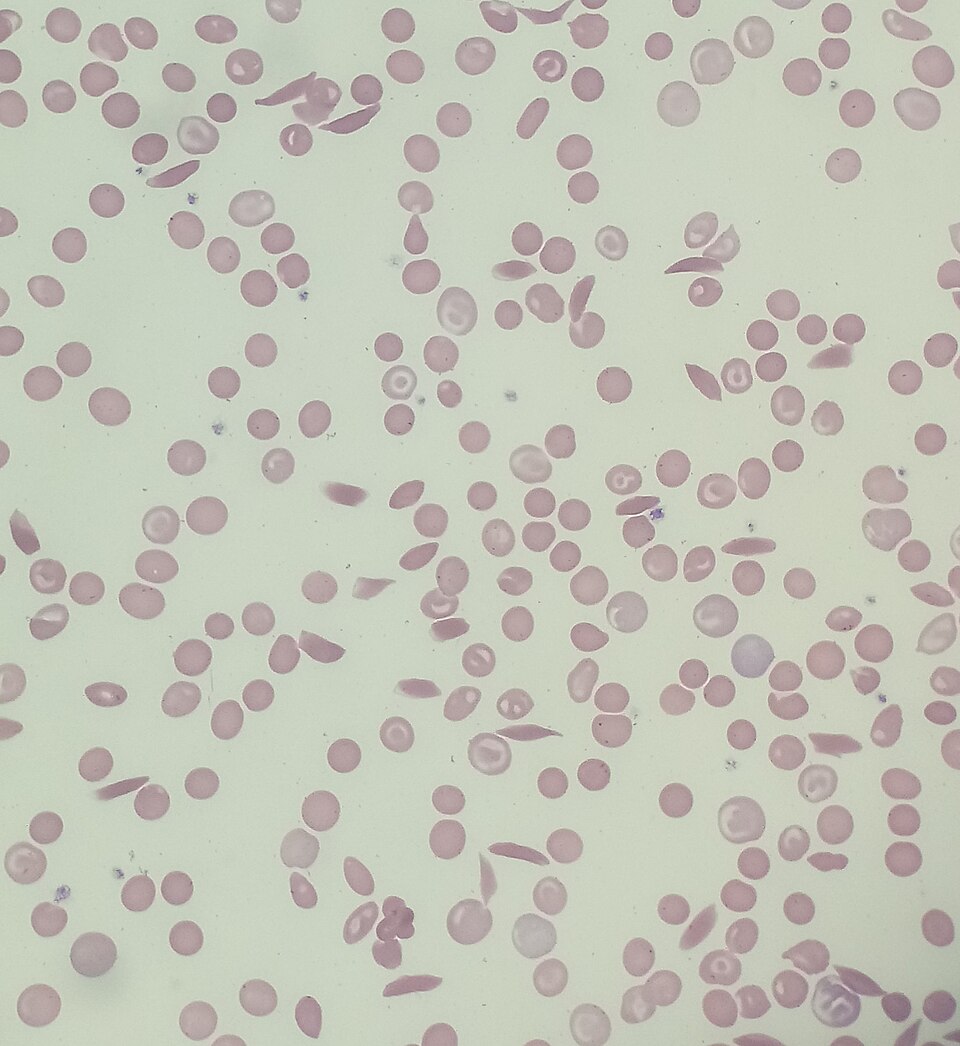
Blood smear showing sickle-shaped red blood cells alongside normal round red blood cells

Overview
- The Hardy-Weinberg principle, independently formulated by G. H. Hardy and Wilhelm Weinberg in 1908, establishes that allele and genotype frequencies in a population remain constant across generations in the absence of evolutionary forces, providing the fundamental null model of population genetics.
- The principle requires five idealized assumptions -- no mutation, no migration, random mating, infinite population size, and no natural selection -- and any departure from the expected genotype frequencies (p-squared + 2pq + q-squared = 1) signals that one or more evolutionary mechanisms are actively changing the genetic composition of the population.
- Hardy-Weinberg equilibrium serves as an indispensable tool in medical genetics for estimating carrier frequencies of recessive disorders, in forensic science for calculating DNA profile match probabilities, and in modern population genomics as a quality-control filter for detecting genotyping errors in genome-wide association studies.
The Hardy-Weinberg principle is the foundational theorem of population genetics. It states that in an idealized population -- one that is infinitely large, randomly mating, and free from mutation, migration, and natural selection -- the frequencies of alleles and genotypes will remain constant from generation to generation. For a locus with two alleles at frequencies p and q, the expected genotype frequencies after a single generation of random mating are p2, 2pq, and q2, a relationship expressed as p2 + 2pq + q2 = 1.1, 2 Independently formulated in 1908 by the English mathematician G. H. Hardy and the German physician Wilhelm Weinberg, the principle provides the null hypothesis against which all evolutionary change is measured: any departure from these expected proportions indicates that one or more evolutionary forces are acting on the population.1, 3
The significance of the Hardy-Weinberg principle lies not in its assumptions, which are never perfectly satisfied in nature, but in its power as a baseline. Just as Newton's first law describes what happens to a body in the absence of external forces, the Hardy-Weinberg principle describes what happens to allele frequencies in the absence of evolutionary forces. By establishing this equilibrium as the expected state, the principle transforms population genetics from a qualitative enterprise into a quantitative science, providing a precise mathematical framework for detecting and measuring selection, drift, mutation, migration, and non-random mating in real populations.2, 5
Historical origins
The Hardy-Weinberg principle emerged from a specific intellectual controversy in early twentieth-century genetics. Following the rediscovery of Mendel's laws in 1900, a sharp debate developed between the Mendelians and the biometricians over the nature of heredity and its relationship to evolution. In 1902, the statistician G. Udny Yule attempted to reconcile Mendel's laws with Galton's ancestral law of heredity, and in doing so derived what is essentially the Hardy-Weinberg relationship for the special case of equal allele frequencies, though his treatment contained errors regarding Mendel's law of segregation.6, 2
The immediate impetus for Hardy's 1908 paper was a question raised at a meeting of the Royal Society of Medicine. The geneticist Reginald Punnett had been challenged by Yule about the expected fate of a dominant trait such as brachydactyly (shortened fingers) in a randomly mating population. If brachydactyly were dominant, Yule argued, should it not inevitably increase in frequency until it affected three-quarters of the population? Punnett was unable to answer satisfactorily, and the next day he described the problem to his colleague, the pure mathematician G. H. Hardy, reputedly while they were waiting to bat during a cricket match at Cambridge.2, 4
Hardy found the solution trivially simple -- he later expressed mild embarrassment at publishing so elementary a result -- and wrote a brief letter to the journal Science demonstrating that in a randomly mating population, the proportions of dominant and recessive phenotypes would remain stable indefinitely, not shift toward a three-to-one ratio. The key insight was that Mendelian segregation, by itself, does not change allele frequencies: a population at Hardy-Weinberg equilibrium reproduces the same genotype frequencies generation after generation, regardless of whether one allele is dominant or recessive.1, 2
Unknown to Hardy and to the English-speaking genetics community, the German physician Wilhelm Weinberg had independently presented the same result several months earlier, on 13 January 1908, in a lecture to the Society for Natural History in Stuttgart. Weinberg's contribution was published in German in the proceedings of the Württemberg Society for Natural Science, a journal with limited international circulation.3, 4 The principle was known as "Hardy's law" in the English-speaking world for thirty-five years until, in 1943, the geneticist Curt Stern drew attention to Weinberg's prior and independent derivation and proposed the name "Hardy-Weinberg law," which has been standard usage ever since.3 As Crow noted in a centennial retrospective, the delay in recognizing Weinberg's contribution was largely a consequence of language barriers: Weinberg published in German at a time when the leading genetics journals were overwhelmingly Anglophone, and his work was simply not read by the researchers who most needed it.4
The mathematical model
The derivation of the Hardy-Weinberg equilibrium is straightforward and requires only the assumption of random mating at a single autosomal locus with two alleles. Let allele A occur at frequency p and allele a at frequency q in a population, where p + q = 1. Under random mating, the probability that an individual receives two A alleles is p × p = p2, the probability of receiving one allele of each type is 2 × p × q = 2pq (because the A may come from either parent), and the probability of receiving two a alleles is q × q = q2. The genotype frequencies AA, Aa, and aa are therefore p2, 2pq, and q2, respectively, and their sum is p2 + 2pq + q2 = (p + q)2 = 1.1, 7
A crucial property of this result is that equilibrium is reached after a single generation of random mating, regardless of the initial genotype frequencies, provided the allele frequencies are the same in males and females. Once the population has attained Hardy-Weinberg proportions, both allele and genotype frequencies remain constant in all subsequent generations, assuming the five equilibrium conditions continue to hold.1, 8 Hardy demonstrated this by showing that if the genotype frequencies in one generation are p2, 2pq, and q2, the allele frequency of A in the gamete pool is p2 + ½(2pq) = p2 + pq = p(p + q) = p, which is unchanged. The same calculation shows that the frequency of a remains q. Random union of gametes in the next generation therefore produces the same genotype frequencies, and the cycle repeats indefinitely.1
This algebraic simplicity belies the principle's conceptual importance. Before Hardy and Weinberg's work, it was widely believed that dominance would cause dominant alleles to increase in frequency at the expense of recessive alleles -- the error that had confused Yule and Punnett. The principle showed conclusively that dominance has no effect on allele frequencies: a recessive allele at frequency q = 0.01, for example, will remain at that frequency indefinitely in the absence of evolutionary forces, even though 99 percent of the individuals carrying the allele are heterozygous carriers in whom it is phenotypically invisible.1, 2
Hardy-Weinberg genotype frequencies as a function of allele frequency p1, 8
| Allele frequency (p) | AA (p2) | Aa (2pq) | aa (q2) |
|---|---|---|---|
| 0.01 | 0.0001 | 0.0198 | 0.9801 |
| 0.10 | 0.0100 | 0.1800 | 0.8100 |
| 0.30 | 0.0900 | 0.4200 | 0.4900 |
| 0.50 | 0.2500 | 0.5000 | 0.2500 |
| 0.70 | 0.4900 | 0.4200 | 0.0900 |
| 0.90 | 0.8100 | 0.1800 | 0.0100 |
| 0.99 | 0.9801 | 0.0198 | 0.0001 |
The five assumptions
The Hardy-Weinberg principle holds exactly only when five conditions are met. Each assumption corresponds to the absence of a specific evolutionary force, and the violation of each produces a characteristic pattern of departure from equilibrium expectations.7, 8
The first assumption is no mutation. Mutation introduces new alleles into a population or converts existing alleles from one form to another, thereby altering allele frequencies over time. In practice, per-locus mutation rates are extremely low -- on the order of 10−5 to 10−8 per generation in most organisms -- so mutation alone changes allele frequencies very slowly and produces negligible departures from Hardy-Weinberg proportions over short timescales. However, mutation provides the ultimate source of all genetic variation upon which the other evolutionary forces act.7, 8
The second assumption is no migration (also called no gene flow). Migration introduces alleles from other populations that may have different allele frequencies, shifting the recipient population's frequencies toward those of the source population. The magnitude of the effect depends on the migration rate and the difference in allele frequencies between the populations. Even modest levels of gene flow can prevent populations from diverging genetically, homogenizing allele frequencies across the species range.8, 13
The third assumption is random mating (panmixia). Hardy-Weinberg equilibrium requires that mate choice be independent of genotype at the locus in question. Non-random mating does not change allele frequencies -- this is a critical distinction -- but it does alter genotype frequencies away from Hardy-Weinberg proportions. The most common form of non-random mating is assortative mating, in which individuals preferentially mate with others of similar phenotype, which increases the frequency of homozygotes relative to Hardy-Weinberg expectations. Inbreeding, the mating of related individuals, is a special case that increases homozygosity across the entire genome. Conversely, disassortative mating, in which individuals preferentially mate with dissimilar partners, increases heterozygosity above Hardy-Weinberg expectations.7, 8
The fourth assumption is infinite population size (no genetic drift). In finite populations, allele frequencies fluctuate randomly from generation to generation due to the chance sampling of gametes, a process known as genetic drift. The magnitude of drift is inversely proportional to the effective population size: smaller populations experience larger random fluctuations and more rapid loss of genetic variation. Drift can cause allele frequencies to depart from Hardy-Weinberg expectations, particularly in very small populations, and over time can lead to the fixation or loss of alleles regardless of their fitness effects.7, 13
The fifth assumption is no natural selection. If individuals with certain genotypes survive and reproduce at different rates than individuals with other genotypes -- that is, if there are fitness differences among genotypes -- then allele frequencies will change across generations in a directional, non-random manner. Selection can produce departures from Hardy-Weinberg equilibrium within a single generation if it acts between the formation of zygotes and the census of adults, creating a deficit or excess of particular genotypes relative to the Hardy-Weinberg expectation.7, 8, 16
Detecting departures from equilibrium
The practical utility of the Hardy-Weinberg principle rests on the ability to test whether an observed set of genotype frequencies conforms to the expected proportions. Several statistical methods have been developed for this purpose, each with distinct strengths depending on sample size, number of alleles, and the specific alternative hypothesis of interest.9
The simplest and most widely used approach is the chi-squared goodness-of-fit test. Given a sample of n individuals with observed genotype counts nAA, nAa, and naa, one first estimates the allele frequencies as p̂ = (2nAA + nAa) / 2n and q̂ = 1 − p̂, then calculates the expected genotype counts under Hardy-Weinberg proportions, and finally computes the chi-squared statistic comparing observed and expected counts. For a biallelic locus, this test has one degree of freedom. However, the chi-squared approximation performs poorly when expected cell counts are small, a situation that commonly arises when one allele is rare.9, 8
For small samples and rare alleles, exact tests are preferred. The exact test for Hardy-Weinberg equilibrium, based on the conditional distribution of heterozygote counts given the observed allele counts, provides an exact p-value without relying on asymptotic approximations. Guo and Thompson developed computationally efficient algorithms using Markov chain Monte Carlo methods to perform exact tests at loci with multiple alleles, where the number of possible genotype configurations is too large for complete enumeration.10 Wigginton, Cutler, and Abecasis later demonstrated that exact tests are computationally feasible even for the hundreds of thousands of markers examined in genome-wide studies, and that the commonly used chi-squared test can produce inflated Type I error rates at markers with low minor allele frequency, making exact tests the preferred method for large-scale genomic analyses.11
Emigh provided the first comprehensive comparison of test statistics for Hardy-Weinberg equilibrium, evaluating the chi-squared test, the likelihood ratio test, and an exact test under a range of sample sizes and allele frequencies. His analysis showed that the exact test is consistently the most reliable across all conditions, while the chi-squared and likelihood ratio tests perform well only when sample sizes are large and allele frequencies are intermediate.9 These findings have been confirmed and extended by subsequent work, and the exact test is now the standard approach in most population-genetic and genomic applications.11, 13
Interpreting a significant departure from Hardy-Weinberg equilibrium requires careful consideration of the possible causes. Waples identified several categories of explanation for observed departures: genuine biological forces acting on the population (selection, non-random mating, population substructure), technical artefacts of sample collection or genotyping (pooling of individuals from genetically distinct subpopulations, called the Wahlund effect, or systematic genotyping errors), and statistical artefacts (multiple testing across thousands of loci, small sample sizes). Disentangling these explanations is essential, because the appropriate response to a departure depends on its cause.13
Common causes of departures from Hardy-Weinberg equilibrium8, 13
| Cause | Effect on genotype frequencies | Changes allele frequencies? |
|---|---|---|
| Inbreeding | Excess homozygotes, deficit of heterozygotes | No |
| Assortative mating | Excess homozygotes at selected loci | No |
| Population substructure (Wahlund effect) | Excess homozygotes when subpopulations are pooled | No (within subpopulations) |
| Natural selection against heterozygotes | Deficit of heterozygotes | Yes |
| Balancing selection (heterozygote advantage) | Excess heterozygotes | Yes (toward stable equilibrium) |
| Genotyping error | Usually deficit of heterozygotes | Apparent, not real |
| Null alleles | Apparent excess of homozygotes | Apparent, not real |
Deviations as evidence of evolutionary forces
Because the Hardy-Weinberg principle specifies the genotype frequencies expected in the absence of evolutionary forces, systematic departures from those expectations serve as a powerful diagnostic tool for identifying which forces are acting on a given locus or population. The direction of the departure -- whether it involves an excess or a deficit of heterozygotes, or a shift in allele frequencies over time -- provides information about the nature of the underlying evolutionary process.8, 16
A deficit of heterozygotes relative to Hardy-Weinberg expectations is the most commonly observed departure in natural populations and can result from several causes. Inbreeding, the mating of close relatives, increases the probability that an individual receives identical-by-descent alleles from both parents, thereby increasing homozygosity across all loci simultaneously. Wright's inbreeding coefficient F quantifies this departure: the frequency of heterozygotes in an inbred population is 2pq(1 − F), where F ranges from 0 (random mating) to 1 (complete inbreeding).7, 8 The Wahlund effect produces a similar genome-wide pattern of heterozygote deficit: when individuals from two or more genetically distinct subpopulations with different allele frequencies are inadvertently pooled into a single sample, the combined sample will show fewer heterozygotes than expected, even if each subpopulation individually conforms to Hardy-Weinberg proportions.8, 13
An excess of heterozygotes is rarer in practice but diagnostically significant. Heterozygote advantage (overdominance), in which heterozygous individuals enjoy higher fitness than either homozygous class, maintains both alleles in the population at a stable equilibrium and can produce a measurable excess of heterozygotes relative to Hardy-Weinberg expectations. The classic example is the sickle-cell allele (HbS) in human populations exposed to Plasmodium falciparum malaria: heterozygous carriers (HbA/HbS) are protected against severe malaria and have higher fitness than either homozygous class, maintaining the HbS allele at frequencies up to 20 percent in some West African populations despite the severe pathology of sickle-cell disease in HbS/HbS homozygotes.8, 16
Departures at individual loci, rather than genome-wide, often signal locus-specific selection. If a genome-wide survey reveals that the vast majority of loci conform to Hardy-Weinberg proportions but a small number show significant departures, the deviant loci are candidates for the action of natural selection, and the pattern of departure can indicate the mode of selection. An excess of rare alleles across the genome may indicate recent population expansion, while an excess of intermediate-frequency variants at specific loci may indicate balancing selection.16, 13
Applications in medical genetics
One of the most practically important applications of the Hardy-Weinberg principle is in medical genetics, where it enables the estimation of carrier frequencies for autosomal recessive disorders from the observed incidence of affected individuals. For a recessive condition caused by a single locus with two alleles, the frequency of affected individuals (homozygous recessive) in the population equals q2. If the disease incidence is known, q can be estimated as the square root of the incidence, and the carrier frequency (heterozygous individuals) is approximately 2pq ≈ 2q when the disease allele is rare (p ≈ 1).7, 8
Consider cystic fibrosis, the most common life-threatening autosomal recessive disorder in populations of European descent. The incidence of cystic fibrosis is approximately 1 in 2,500 live births among individuals of Northern European ancestry, giving q2 = 1/2,500 = 0.0004, q = 0.02, and the carrier frequency 2pq ≈ 2 × 0.98 × 0.02 ≈ 0.039, or approximately 1 in 25. This calculation, grounded entirely in the Hardy-Weinberg principle, reveals that although only 1 in 2,500 individuals is affected, approximately 1 in 25 is a heterozygous carrier of the disease allele -- a far larger proportion than one might intuitively expect.8
Similarly, phenylketonuria (PKU) occurs at a frequency of approximately 1 in 10,000 births in many European populations, yielding q = 0.01 and a carrier frequency of approximately 1 in 50. For rarer conditions, the disparity between affected and carrier frequencies becomes even more dramatic: a disorder with an incidence of 1 in 1,000,000 (q = 0.001) has a carrier frequency of approximately 1 in 500 -- two thousand times as many carriers as affected individuals. This mathematical relationship explains why autosomal recessive disorders can persist in populations at surprisingly high frequencies despite the low fitness of affected homozygotes: the vast majority of disease alleles are sheltered from selection in phenotypically normal heterozygous carriers.7, 8
Hardy-Weinberg-based carrier frequency estimation has become a standard tool in genetic counselling. When a couple with no family history of a recessive disorder seeks to assess their reproductive risk, the Hardy-Weinberg principle provides the prior probability that each partner is a carrier, which can then be updated with family history and molecular test results using Bayesian methods. The principle is also central to newborn screening programmes, which use population-level disease frequencies to determine which conditions are sufficiently common to justify universal screening.8
Carrier frequencies for selected autosomal recessive disorders in European populations, estimated from Hardy-Weinberg equilibrium7, 8
Applications in forensic science
The Hardy-Weinberg principle is equally fundamental to forensic genetics, where it provides the mathematical basis for calculating the probability that a randomly chosen individual from a population matches a given DNA profile. Modern forensic DNA profiling examines multiple polymorphic loci, typically short tandem repeats (STRs), each of which may carry many different alleles. The probability of a particular genotype at a single locus is calculated using Hardy-Weinberg proportions: pi2 for a homozygous genotype with allele frequency pi, and 2pipj for a heterozygous genotype with allele frequencies pi and pj. The overall match probability for a multi-locus profile is then obtained by multiplying the single-locus probabilities across all loci, invoking the principle of independent assortment for unlinked markers.14
The second National Research Council report on forensic DNA evidence, published in 1996, recommended the use of Hardy-Weinberg proportions for calculating genotype frequencies at individual loci, while acknowledging the need to account for possible departures due to population substructure. When the population from which a suspect is drawn may contain genetically differentiated subgroups, the simple Hardy-Weinberg formula can underestimate the match probability because allele frequencies vary among subgroups. To address this, the NRC report recommended the use of a correction factor based on Wright's FST statistic (also denoted θ), which adjusts the genotype frequency calculation to account for the excess homozygosity expected in a subdivided population.14
The validity of Hardy-Weinberg assumptions in forensic contexts has been extensively tested. Large-scale database studies have confirmed that, at the STR loci used in forensic profiling, genotype frequencies in reference populations generally conform to Hardy-Weinberg expectations, supporting the use of the product rule for calculating multi-locus match probabilities. Significant departures from Hardy-Weinberg proportions at specific loci in a forensic database may indicate genotyping errors, null alleles (alleles that fail to amplify during PCR, causing heterozygotes to be scored as homozygotes), or the presence of population substructure -- all of which require investigation before the data can be used reliably in casework.14, 13
Extensions to multiple alleles and X-linked loci
The basic Hardy-Weinberg model for two alleles at an autosomal locus generalizes straightforwardly to loci with multiple alleles. For a locus with k alleles at frequencies p1, p2, ..., pk (where Σpi = 1), the expected frequency of homozygous genotype AiAi is pi2 and the expected frequency of heterozygous genotype AiAj (where i ≠ j) is 2pipj. The total number of distinct genotypes is k(k + 1)/2, and the Hardy-Weinberg genotype frequencies are given by the terms of the multinomial expansion (p1 + p2 + ... + pk)2 = 1.7, 8 Testing for Hardy-Weinberg equilibrium at multiallelic loci is computationally more demanding than for biallelic loci because the number of possible genotype configurations grows rapidly with the number of alleles. The exact test algorithms developed by Guo and Thompson using Markov chain Monte Carlo methods addressed this challenge and remain the standard approach for highly polymorphic loci such as the human leukocyte antigen (HLA) system and forensic STR markers.10
The extension of the Hardy-Weinberg principle to X-linked (sex-linked) loci requires modification because males are hemizygous at X-linked loci, carrying only one allele rather than two. For an X-linked locus with alleles at frequencies p and q, the expected genotype frequencies differ between the sexes: females, who are diploid at the X chromosome, have genotype frequencies p2, 2pq, and q2, exactly as for an autosomal locus; males, who carry a single X chromosome, have allele (genotype) frequencies p and q directly. An important consequence is that recessive X-linked phenotypes are expressed much more frequently in males than in females -- a male expresses the recessive phenotype at frequency q, while a female expresses it at frequency q2 -- explaining the well-known sex bias in conditions such as red-green colour blindness and haemophilia.7, 8
Equilibrium at an X-linked locus is reached more slowly than at an autosomal locus. If allele frequencies differ between males and females in the initial generation, the approach to equilibrium is oscillatory, with the difference in allele frequency between the sexes halving and reversing sign with each generation. The frequencies converge to a weighted average, with the female frequency receiving twice the weight of the male frequency because females carry two-thirds of the X chromosomes in the population. Graffelman and Weir developed exact tests specifically designed for Hardy-Weinberg equilibrium at X-linked biallelic markers, accounting for the different genotype expectations in males and females and providing more appropriate statistical methods than simply applying autosomal tests to X-linked data.15
Role in modern population genomics
In the era of genome-wide association studies (GWAS) and whole-genome sequencing, the Hardy-Weinberg principle has acquired a new and critical role as a quality-control filter. When hundreds of thousands or millions of genetic markers are genotyped simultaneously, systematic genotyping errors at individual markers can produce spurious associations with disease phenotypes. Because genotyping errors typically produce an apparent deficit of heterozygotes -- for example, when a heterozygous genotype is miscalled as homozygous due to allele dropout or probe failure -- testing for Hardy-Weinberg equilibrium in control samples serves as an efficient screen for problematic markers.11, 12
Salanti and colleagues evaluated Hardy-Weinberg equilibrium testing in 239 published genetic association studies and found that only 63 percent reported any information on Hardy-Weinberg proportions in their control samples. Among the studies that could be reanalysed, 13 percent showed significant departures from Hardy-Weinberg equilibrium in controls, but only a fraction of the affected studies had acknowledged the departures in their published reports. Because departures from Hardy-Weinberg equilibrium in controls can indicate genotyping error, population stratification, or other problems that invalidate the association analysis, the routine omission of this basic quality check represented a significant gap in the literature.12
Current best practice in GWAS quality control involves testing each marker for Hardy-Weinberg equilibrium in the control sample and excluding markers that fall below a specified significance threshold. The appropriate threshold must balance the competing risks of discarding correctly genotyped markers (false positives of the Hardy-Weinberg test) and retaining erroneously genotyped markers (false negatives). Wigginton, Cutler, and Abecasis demonstrated that the exact test is computationally feasible at genome-wide scale and provides better control of Type I error than the chi-squared test, particularly for markers with low minor allele frequencies, which are disproportionately prone to genotyping error.11
Beyond quality control, Hardy-Weinberg equilibrium testing in genomic datasets can reveal genuine biological signals. Departures from equilibrium in case samples but not in controls may indicate the action of selection on disease-associated loci. Systematic genome-wide departures may reveal population substructure or cryptic relatedness among study participants that, if unaccounted for, can inflate the false-positive rate of association tests. The Hardy-Weinberg principle thus serves a dual function in modern genomics: as a technical quality filter and as a biological signal detector.11, 13
Waples cautioned, however, that the interpretation of Hardy-Weinberg test results in large genomic datasets requires careful attention to multiple-testing issues. When millions of markers are tested simultaneously, even a small proportion of false positives can produce a large number of apparently significant departures purely by chance. Conversely, applying overly stringent correction for multiple testing can cause genuine departures to be dismissed. Waples advocated a two-stage approach in which markers showing departures from Hardy-Weinberg proportions are first identified, and then the pattern and magnitude of the departures are examined to distinguish technical artefacts from biologically meaningful signals.13
Significance as a null model
The Hardy-Weinberg principle occupies a singular position in evolutionary biology as the discipline's most fundamental null model. Its role is analogous to that of the ideal gas law in thermodynamics or Newton's first law in mechanics: it describes the default state of a system in the absence of perturbing forces, and its value lies precisely in the fact that the real world deviates from it in informative ways.2, 5 Every major advance in population genetics can be understood as the systematic exploration of what happens when one or more Hardy-Weinberg assumptions are violated: Fisher, Wright, and Haldane built the mathematical architecture of the modern evolutionary synthesis by analysing the consequences of selection and drift on allele frequencies; Kimura's neutral theory reformulated the null model at the molecular level; and modern population genomics uses Hardy-Weinberg departures to detect selection, infer demographic history, and assess data quality.5, 16
Mayo, in a centennial review, argued that the Hardy-Weinberg principle's enduring importance stems from its simplicity, its generality, and its falsifiability. It is simple enough to be taught in introductory biology courses, general enough to apply to any diploid sexually reproducing organism, and falsifiable enough to serve as a genuine scientific hypothesis that can be tested with empirical data. No other single result in population genetics has had such a pervasive influence on the development of the field.5
The principle also played a crucial historical role in the development of the modern evolutionary synthesis by resolving the confusion between dominance and allele frequency change. Before Hardy and Weinberg's work, even sophisticated geneticists believed that dominant alleles would inevitably increase in frequency and recessive alleles would inevitably disappear. By showing that Mendelian inheritance, by itself, preserves allele frequencies unchanged, the principle cleared the conceptual ground for understanding that evolutionary change requires the action of external forces -- selection, drift, mutation, or migration -- and that the rate and direction of change depend on the magnitude and nature of those forces.1, 2, 4
More than a century after its formulation, the Hardy-Weinberg principle remains indispensable. It is the starting point for every population-genetic calculation, the baseline for every test of evolutionary hypotheses, and the conceptual cornerstone of a discipline that now spans applications from ancient DNA analysis to precision medicine. Its derivation requires only elementary algebra, yet its implications are profound: in a world where allele frequencies tend to remain stable, evolution is not the default state of populations but a consequence of specific identifiable forces acting upon them.2, 5, 7
References
Hardy-Weinberg equilibrium in genetic association studies: an empirical evaluation of reporting, deviations, and power
Testing for Hardy-Weinberg equilibrium at biallelic genetic markers on the X chromosome